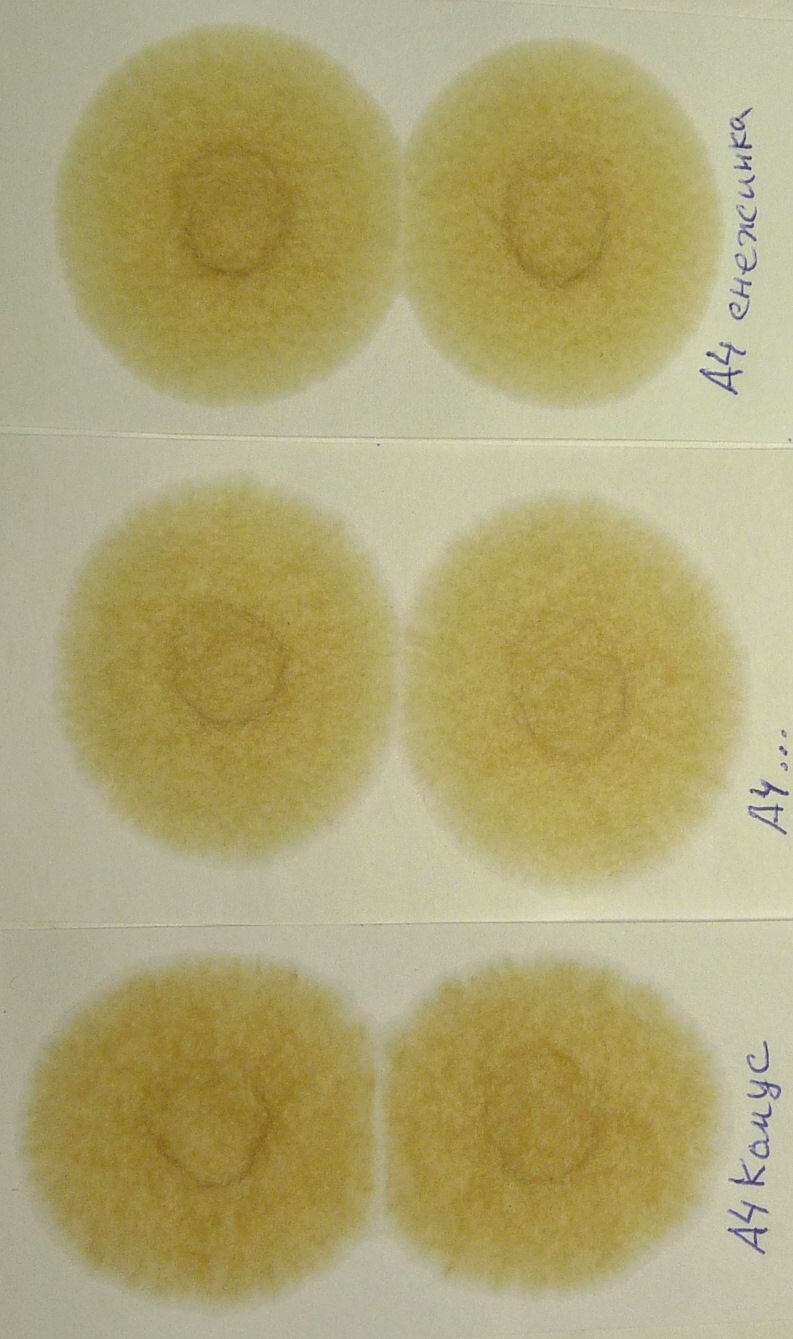

Качество масла по капле
Канае гуль
Рецепт из войлочной вишни на зиму
Может ли сгореть катушка зажигания
Белорусские электростанции
Работа в наволоках
Нужно но в количестве не
Фонбет первая лига 2025 2025
Индивидуальная работа с детьми старшая группа март
Koi dekinai no wa kimi no
Города на физической карте
Таблица светоощущения
Можно ли ездить на шипованной резине зимой
13 сентября 2025г
Качество масла по капле 110 фотографий